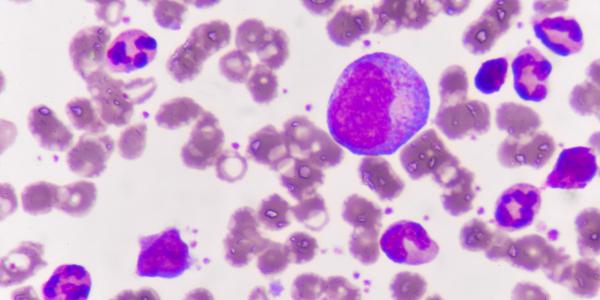

Research Stories
Recent Research Stories From Across UBC

UBC researchers establish performance assessment guidelines for local water utilities

Discover UBC's Response to COVID-19

Climate change an imminent threat to B.C.’s ‘living dinosaurs’

Cracking the complex biology of cannabis

Protecting Canadian forests through applied biosurveillance research

Fusing Satellite Images to Detect Fire Patterns

Majority of cannabis use in Vancouver’s DTES for therapeutic purposes, may also reduce opioid overdose risk

UBC Sauder research helps determine treatment plans for kidney patients across North America

UBC Researched explores reconciliation in contested landscapes

UBC scientist identifies a gene that controls thinness

UBC researchers develop biodegradable medical mask for COVID-19
New combination treatment may overcome drug resistance in blood cancers